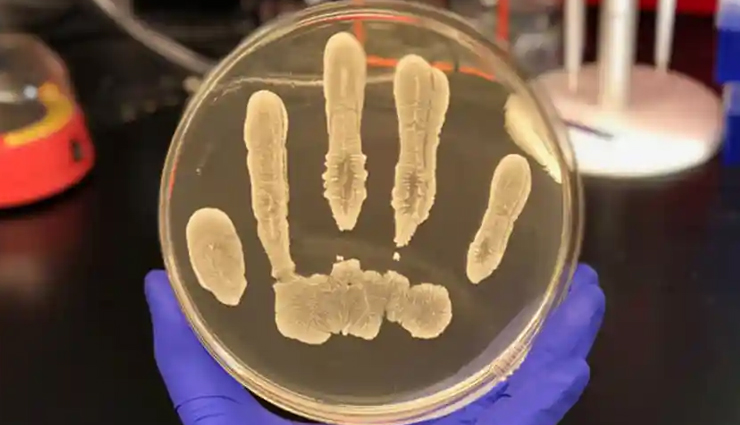
celery,health benefits of celery,Health tips,fitness tips

- Home›
- Healthy Living›
- 6 Health Benefits Of Eating Celery
6 Health Benefits Of Eating Celery
By: Kratika Maheshwari Thu, 18 Nov 2021 10:26:20

Celery is an herbaceous plant of the parsley family ( Apiaceae) and its stalks and leaves are used to flavor soups and stocks. It is low in calories, has high water content, and is used as a low-carb snack option.
Celery is native to Mediterranean and North African areas but is now cultivated globally. It is a popular ingredient in cuisines from America and Ireland to Japan and Australia.
Celery is known for its medicinal benefits. It is antibacterial, anti-inflammatory, and anti-diabetic. Celery juice provides many other benefits such as curing skin irritations, promotes weight loss, and promotes detoxification.

# Provide Anti-Inflammatory Benefits
As per the 2019 study, cytokines in celery leaves provide anti-inflammatory benefits and act as an immune system messenger molecule.
Bioactive inflammatory compounds such as apigenin, luteolin, and kaempferol in celery provide relief from pain and inflammation caused by inflammatory conditions such as arthritis, rheumatism, rheumatoid, gouts, asthma, and bronchial asthma.
# Protection Against Cancer(s)
Vitamin C, vitamin A, and other antioxidant compounds such as flavonoids like apigenin and luteolin in celery protect our cells from free radical damage.
It reduces the risk of various cancers such as colon cancer, breast cancer, pancreatic cancer, abdominal cancer, and intestinal cancer, etc.Free radicals are the unstabilized ions that stabilize by stealing electrons from neighboring molecules and doing so causes oxidative damage to themApigenin and luteolin may kill cancer cells in the body.

# May Help Treat Vitiligo
As per a study conducted in Poland, the furanocoumarins in Celery may help treat vitiligo.
Vitiligo is a condition that causes skin discoloration and the formation of white patches due to a lack of pigment in certain areas of the skin.Ancient ayurvedic texts such as Atharva Veda also mention the use of celery for vitiligo treatment.

# Lowers LDL Cholesterol
Dietary fiber in celery reduces LDL cholesterol and manages cholesterol levels in our body.
Phthalates in celery stimulate the secretion of bile juices, which work to reduce cholesterol levels in our body.By reducing LDL cholesterol, it minimizes the risk of atherosclerosis.
Atherosclerosis is a condition that hardens and narrows our arteries due to the accumulation of plaque and fat deposits in arterial walls.

# May Reduce Blood Pressure
As per a 2009 study, organic compounds such as phthalides in celery may lower stress hormones in the blood and have hypolipidemic effects on our bodies. They expand our blood vessels, improve blood circulation and provide relief from hypertension or high blood pressure.
Hypertension or high blood pressure is a common health condition that affects millions around the world and causes cardiovascular and other health problems.

# May Promote Neurogenesis And Prevent Memory Loss
Bioactive compounds such as Luteolin and Apigenin in celery may reduce the risk of memory loss.As per a study conducted at the Jinan University ( China), Luteolin ( a flavonoid in celery) calms brain inflammation and may help in the treatment of neuroinflammatory disorders.
It reduces the risk of neurodegenerative diseases such as Parkinson’s disease, Alzheimer’s disease, etc.





